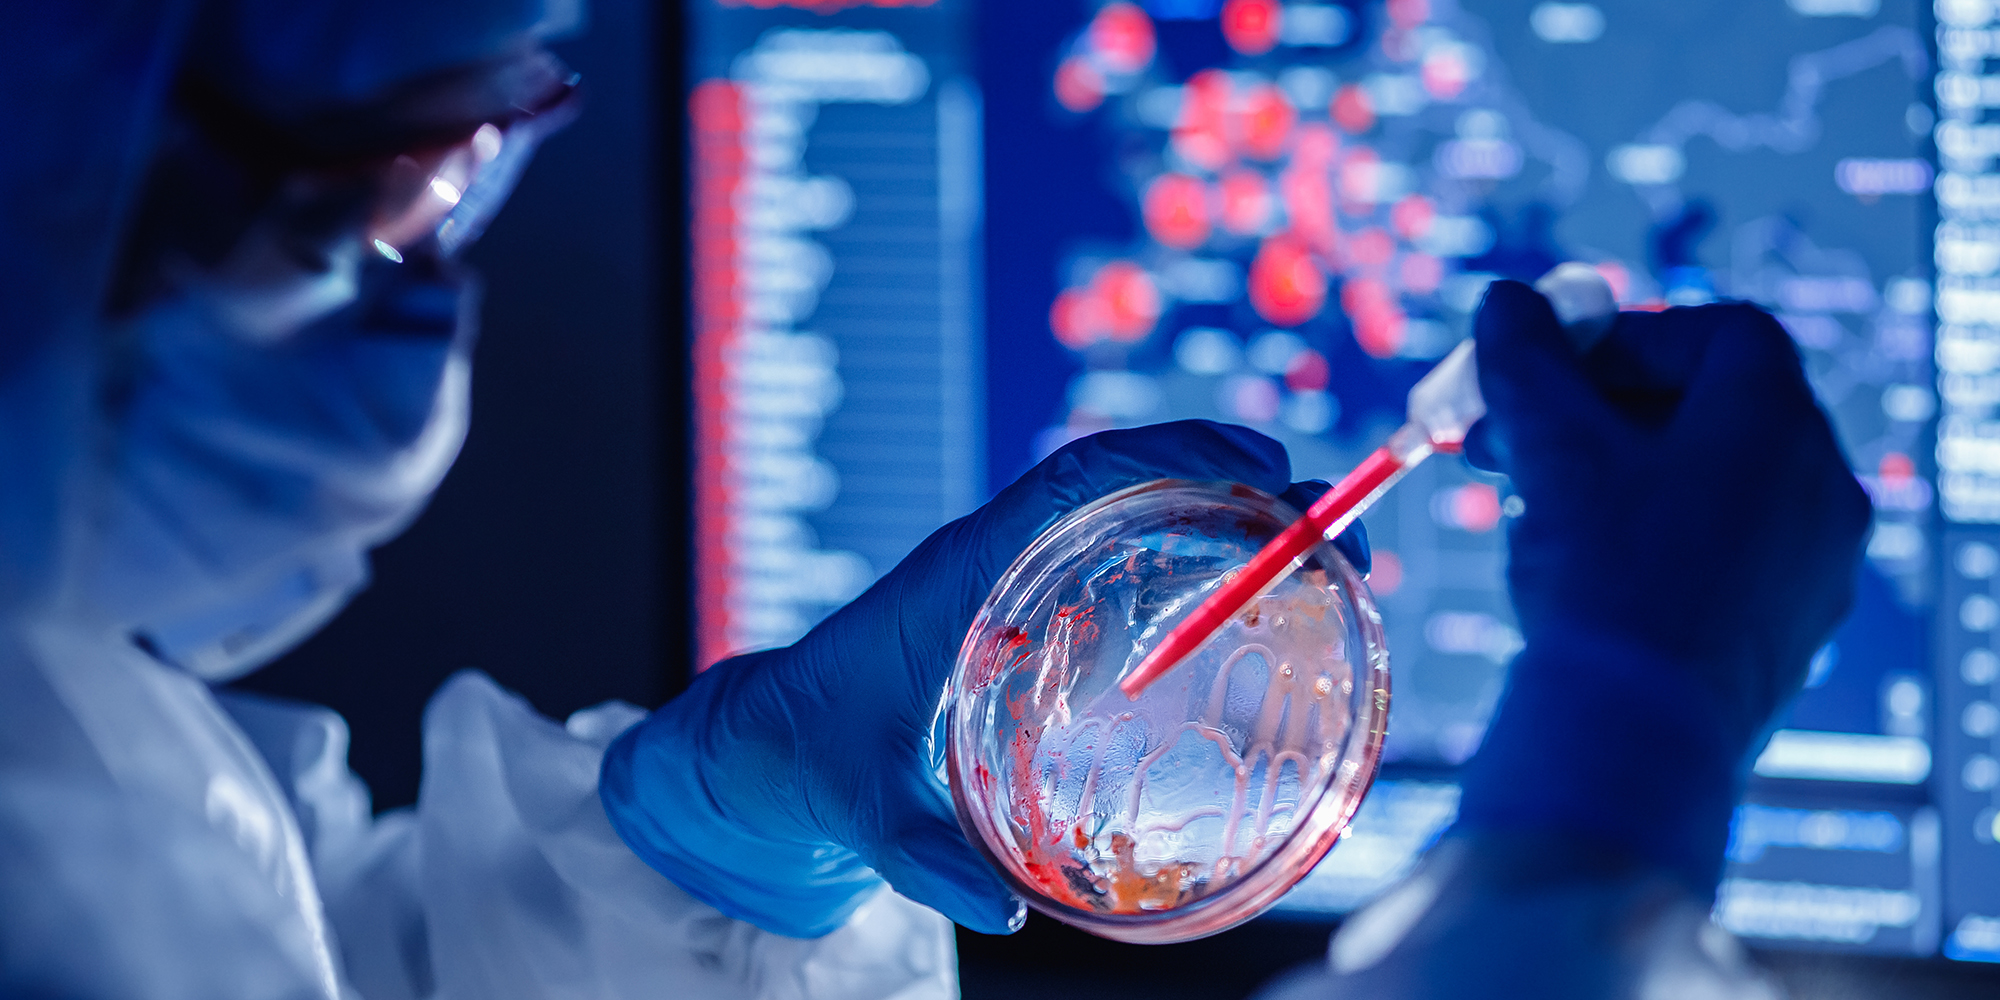
Wastewater surveillance is an early-warning system for Covid-19 outbreaks

In July, we wrote and recommended in Daily Maverick on South Africa needing a Covid-19 wastewater and water-quality surveillance programme. This was after the Water Research Commission (WRC) and Salga partnership’s May launch of the water quality (wastewater and non-sewer) national surveillance programme aimed to complement national initiatives in dealing with the pandemic.
The objective of this programme was to pilot and facilitate the implementation of a nationwide initiative for the surveillance of Covid-19 spread in South African communities using a water and sanitation-focused approach to support the current Covid-19 surveillance initiatives, and also to serve as an early warning for the resurgence of the virus and other waterborne disease outbreaks.
Screening municipal wastewater and environmental water quality as an epidemiological tool for viruses is not a new concept and has been used to help inform broader infectious disease epidemiological surveillance and mitigation efforts such as the Global Polio Eradication Initiative. Environmental surveillance has also been used and recommended for other infections, such as typhoid, early warning of hepatitis A and norovirus outbreaks, as well as for antimicrobial resistance, with modelling techniques used to assist the design and interpretation of those efforts. Wastewater-based epidemiology is also commonly used in the surveillance of licit and illicit drugs and various chemical contaminants which may have an impact on human health.
The first phase of the WRC proof-of-concept has just been completed and based on a continuous five weeks of weekly sampling of several wastewater treatment plants in hotspot metros around the country, it has confirmed and shown that 98% of samples tested have conclusively shown the presence of SARS-CoV-2 RNA fragments. The interpretation of this is that “the virus is in the poop”. This is a very significant and important development for South Africa and puts us among the global leaders in the science and development of Covid-19 surveillance. Several other initiatives in the country confirm this situation. More so, this is evidence and confidence that wastewater and water quality surveillance can complement the national individual testing programme.
The study also found that:
Positive results were found when sampling defined populations such as prisons and hospitals upstream of wastewater treatment works (WWTWs), and SARS-CoV-2 RNA was detected at small WWTWs serving industries and mines.
The results indicated an increase in the viral load in the samples being tested with time which corresponded to the increase in case numbers in the hotspots as the peak infection phase of the pandemic was entered.
The wastewater surveillance results mirrored the pattern of prevalence of the viral infections in the community.
The study explored surveillance in non-sewered areas, where conditions can be appalling and densities high, putting residents at higher risk. Measuring samples from runoff water in pools and downstream of these settlements showed positive for both virus RNA recovery and positive gene amplification of SARS-CoV-2. This finding is of concern and requires serious mitigation and intervention.
Similar progress and outcomes in surveillance have been emerging globally. Many countries are seeing the value and have adopted the techniques and process as a national programme, such as Turkey, Spain, Brazil and the UK, while many others, including Canada, Australia and the US are gearing themselves to leapfrog into national monitoring programmes. South Africa forms part of this global network leading the science and development of wastewater surveillance.
In South Africa, the number of people with Covid-19 is most likely underestimated, mainly due to the limitations regarding testing and also due to the probably large number (estimated to be 45%) of asymptomatic individuals. If we can rapidly implement the wastewater surveillance programme in South Africa, the sector will have a tool that provides valuable additional information about the spread of the virus as a complement to health surveillance and also acts as an early warning system for infection in communities, providing a more sensitive and rapid indication of changes in infection rates before such effects become detectable by clinical health surveillance. Critically, this will provide decision support for officials determining the timing and severity of public health interventions to mitigate the overall spread of the disease.
While we enter the period of relaxation of the lockdown levels supported by evidence in the slowdown of the number of cases, as a country we should not be complacent and over-confident, as international experience has shown the surges of the second and third waves. It is possible that the largest waves will start in dense formal and informal settlements. With this anticipation of possible escalations in Covid-19 infections and the challenges associated with individual testing, it is of absolute priority to introduce a nationwide wastewater surveillance programme to complement national interventions.
Wastewater surveillance offers a cost-effective and less invasive means of continuous screening. When increasing trends in viral load are noted then additional clinical test methods could be rolled out based on an early warning system. This effective method of understanding the pandemic trends provides for identifying hotspots and tracks the waves of the transmission as the pandemic unfolds.
This investment is far better than going into another economic lockdown. DM
Jay Bhagwan is an executive manager at the Water Research Commission.

(Photo: Adobe Stock)
(Photo: Adobe Stock)